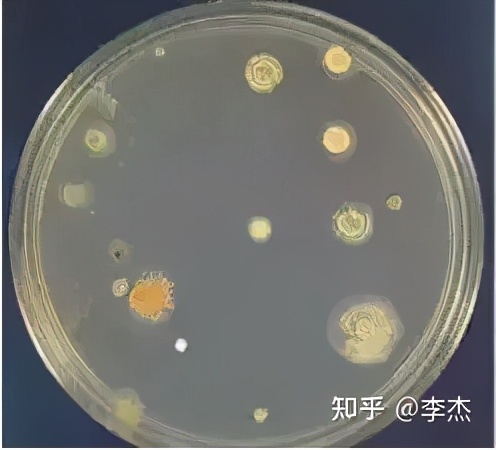
细胞培养出现链球菌污染怎么办,细胞培养如何应对支原体污染
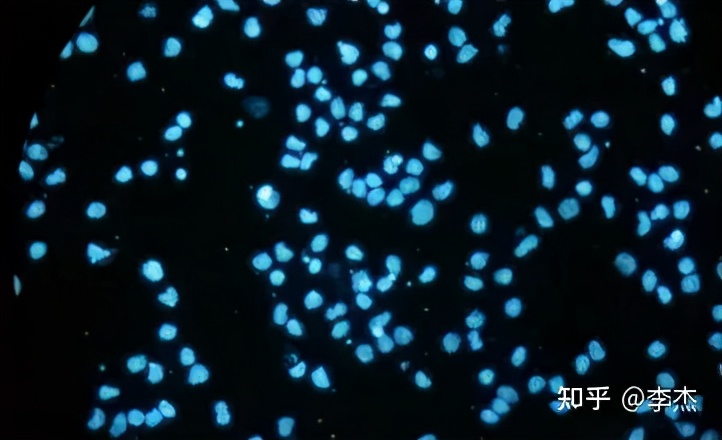
细胞培养出现链球菌污染怎么办,细胞培养如何应对支原体污染

前言
细胞培养物被支原体污染是极普遍的问题,面对支原体污染给细胞培养带来的巨大难题,世界各国开始重视,并相继建立了细胞库,对细胞质量进展控制,效果显著,支原体污染的问题得以限制。目前已知能污染细胞的支原体有20多种以上,其中95%以上的支原体污染是口腔支原体。
目前已知的主要污染源是动物血清、胰酶和已污染培养物的气溶胶,例如,猪鼻支原体通过胰酶,在消化细胞时进入细胞培养物,并造成污染。在原代细胞与传代细胞的检测中,原代细胞与传代细胞分离出支原体的频率是有明显差异的,传代次数越多的细胞,污染支原体的可能性就越大,这也是多次与动物血清、胰酶和已污染培养物的气溶胶接触后造成的,在原代细胞中,污染率低于4%,而传代细胞的污染率则高达57%~92%。
支原体的介绍
支原体是目前已知一类能在无生命培养基上生长繁殖的最小的原核细胞微生物,分为两个属:一为支原体属(Mycoplasma),有几十个种;另一为脲原体属(Ureaplasma),仅有一种。革兰染色为阴性,但不易着色,一般用Giemsa染色,染成淡紫色。
支原体在自然界分布广泛,无细胞壁,直径为0.1-0.3μm,且形态易变,极易通过除菌过滤器。大部分支原体繁殖速度比细菌慢,适宜生长温度为35℃,适合于偏碱条件下生存(pH7.6—8.0),对酸耐受性差,对75%乙醇、煤酚皂溶液敏感。对热比较敏感在细胞培养过程中如果在显微镜下发现破碎的细胞很多,需要频繁换液才能维持传代培养的时候,即应怀疑支原体污染。细胞培养过程中遇到的支原体95%都来自于以下四种支原体:口腔支原体、精氨酸支原体、猪鼻支原体、莱氏无胆甾支原体,其中莱氏无胆甾支原体为牛源性。

细胞受支原体污染严重
(1)据统计世界范围内大约有15%-35%的细胞培养物遭受了支原体污染。
(2)从2013年开始,《Nature》期刊已正式要求投稿的文章,如涉及细胞培养都要进行支原体检测。
(3)欧洲药典规定对细胞治疗产品需要进行严格的支原体检测。
(4)美国FDA规定为了提高细胞生物制品安全性,需要进行支原体污染检测。
(5)中华人民共和国药典规定主细胞库、工作细胞库、病毒种子批、对照细胞以及临床治疗用细胞应进行支原体检测。
支原体的污染来源
(1)细胞之间交叉污染;
(2)细胞培养操作人员的口腔、皮肤等;
(3)工作环境或实验器材的污染;
(4)培养基的污染。

支原体污染示例图
支原体污染的检测及鉴定方法
01、 分离培养法
支原体的病原学检测主要是从被污染的细胞、鸡胚中分离培养出支原体来确定,分离培养法是检测支原体污染中最为可靠准确的方法。但是支原体对环境的影响敏感,容易被灭活,而且分离培养操作相对繁琐,所需时间较长,因此只能够对支原体污染进行定性观察。分离培养法在常规的支原体检测中多用于辅助其它检测方法。
02、 DNA荧光染色法
DNA荧光染色法较分离培养法缩短了检测周期,主要用于细胞培养中污染支原体的检测。DNA荧光染色法正是利用荧光染色剂双苯咪唑(Bisbenzimidzole)Hoechst33258能够结合支原体DNA中的A-T碱基富集区域的原理,被支原体污染的细胞经染色后,其细胞核外与细胞周围可看到许多大小均一的荧光点,即是富含A-T碱基区域的支原体DNA。
03、 PCR技术
PCR作为一种快速、灵敏、特异且简便的基因诊断技术已应用于科学研究和疾病的诊断。根据支原体基因组内的保守序列设计特异引物,对待检样品的核酸进行扩增,通过对扩增产物的大小分析作出诊断。PCR检测技术用于支原体污染的检测,周期短、灵敏度高、特异性好、操作简单且一次可检测大量样品。

04、 酶联免疫吸附试验(ELISA)
ELISA用于支原体污染的检测中,有着良好的特异性和敏感性,一次可以完成大量样品的检测。如今已有LONZA等公司开发了针对细胞中污染支原体的检测试剂盒,具有简便、快速与定量定性检测等特点。
05、 电镜
一般在细胞培养48~72小时,细胞接近汇合前,用胰酶消化细胞制成细胞悬液后进行固定、包埋、切片后才能进行观察。

06、 ERA支原体检测试剂盒
以上的几种方法花费时间都还是比较长的,先达基因用自己的专利技术ERA恒温核酸扩增方法,研制出了更为简单,快捷,准确的支原体检测试剂盒,灵敏度比普通PCR高百倍,可以在恒定的低温条件下进行,而且在30分钟以内就可以得出结果,并且检测范围涵盖130种支原体,是一种比较理想的支原体检测方法。此试剂盒借助荧光定量检测仪显示结果,先达基因也推出了自己的荧光定量检测仪,由于ERA方法为恒温扩增,所以该仪器相对比较便宜而且小巧。

|
方法 |
灵敏度 |
准确性 |
检测范围 |
时间 |
费用 |
工作量 |
|
培养法 |
低 |
假阴性高 |
有的无法进行培养 |
20天 |
高 |
大 |
|
DNA荧光染色法 |
低 |
假阳性高 |
广谱 |
1天 |
高 |
大 |
|
RT-PCR |
高 |
高 |
由引物决定 |
2-4小时 |
高 |
较小 |
|
LAMP |
高 |
假阳性高 |
由引物决定 |
2小时内 |
较低 |
较小 |
|
ERA |
高 |
高 |
广谱130种 |
30min |
低 |
小 |
细胞污染支原体的预防
细胞培养工作中,主要从以下几个方面来预防支原体的污染:
(1)控制环境污染:可以使用支原体清除喷雾进行空间消毒;生物安全柜或超净工作台也要定期消毒;在水浴锅和培养箱的水源中加入消毒试剂。
(2)严格操作要求:工作开始要先用75%酒精消毒手部以及袖口、瓶口等;在进行多种细胞培养操作时,所用器具(如移液枪等)要严格区分。细胞培养实验室应制定严格的管理制度,按照规范的实验程序操作。
(3)保证细胞培养基和器材无菌,器材一般都经过辐射处理,基本可以保证无菌,商业化CD培养基一般也能保证无菌。如实验室有发现支原体感染,已经开启的培养基不宜继续使用。
(4)在培养基中加入适量抗生素:对支原体比较有效的抗生素为四环素类和大环内酯类,如卡那霉素50μg/ml,一些氟喹诺酮也有抑制支原体生长的作用。
支原体污染细胞后,有必要清除支原体,常用方法有:
1)对于非重要的细胞,如培养中的细胞、WCB的细胞等,将培养物与用过的培养基灭活后丢弃即可。对于较为重要的细胞,如来源珍贵或实验室中细胞保藏量较小等可以采用以下(2)-(8)的方法。
2)用MRA处理:用支原体清除剂处理细胞,作用浓度为 25μg/ml,两周可以清除支原体。
3)用清洗纯化法清除支原体污染的方法:细胞营养驯化→优质细胞群的筛选→细胞清洗→反复离心洗涤,其原理是利用离心力、细胞、微生物质量和悬液的浮力差达到清除支原体的目的。由于支原体个体小且除发酵支原体外多为细胞外寄生,所以通过反复洗涤细胞和低速离心换液使其中潜在的支原体数量降低至极限. 如结合敏感抗生素的抑杀作用,可达到更好的效果。
4)药物辅助加温处理:先用药物处理后,再将污染的组织培养物放在41℃培养18小时,可杀死支原体,但对细胞有不良影响。
5)使用支原体特异性血清:用5%的兔支原体免疫血清可去除支原体污染,因特异抗体可抑制支原体生长,故经抗血清处理后11天即转为阴性,并且5个月后仍为阴性。
6)动物体内接种除菌法:把受支原体污染的肿瘤细胞接种在同种动物皮下或腹腔中,借动物免疫系统消灭支原体,而肿瘤细胞却能在体内继续生长,待一定时间后,从体内取出细胞再进行培养繁殖。
7)巨噬细胞吞噬法:从动物腹腔采取巨噬细胞,为排除其它细胞成分,可先进行纯化,然后再加入被支原体污染的细胞培养液中混合培养。在培养过程中,为检查支原体是否已被消除干净,可利用支持物培养法验证,取出支持物逐日染色、镜检观察,至支原体已被消除干净为止。
8)使用支原体清除培养基,每2~3天更换1次新鲜培养液,换液时用无菌的平衡盐溶液洗涤细胞1~2次;期间如果细胞密度过大,请保持细胞密度适当(贴壁细胞可能需要用胰酶消化),并更换新的培养器皿,3天之后,即可见明显清除效果;处理15天后,可以用支原体检测试剂盒进行检测,检测支原体是否杀灭完全;如果仍有支原体残留,可以考虑再处理6天;为避免细胞再次受到“支原体”的污染,以后每隔1个月进行支原体的常规检测,以保证没有新的支原体污染。
注:支原体污染时细胞表现为长得不好,也不死亡,同时,培养基又是清亮的,时间长达一周也没有什么变化,这时基本上可以判断出是支原体污染了。
总结
在细胞培养过程中,支原体感染发生率超过50%。虽然支原体污染的存在并不能说明这些研究发现是无效的,但这种细菌却可以影响数百个基因的表达水平,并且通过与细胞竞争营养物质而阻碍细胞的生长。因而细胞培养过程中的支原体污染是一个世界性难题。
当细胞(特别是传代细胞)被支原体污染后,细胞内的DNA、RNA及蛋白表达发生改变,而细胞的生长率一般并未发生显著的影响,因而细胞被支原体污染一般难以察觉。同时支原体可透过一般过滤膜(0.22-0.45μm),对于生物制药领域而言,小试中我们几乎不会使用0.1μm的除病毒过滤膜来过滤培养基(生产中通常都会进行除病毒来保证原液质量),那么小试结果在支原体污染的情况下就显得不那么可靠了,尤其是科研工作者往往不会在第一时间怀疑自己的培养物受到了支原体的污染。
对于这种情况,支原体污染的预防更为重要,在新的细胞株入库时,做好支原体等相关检验;规范无菌操作;操作人员在细胞培养与配置培养基时避免不必要的交谈、佩戴口罩、手套与帽子;维持实验室环境卫生;做到以上几点基本可以避免支原体的污染。另外,准备一些支原体检测试剂盒也是很有必要的。